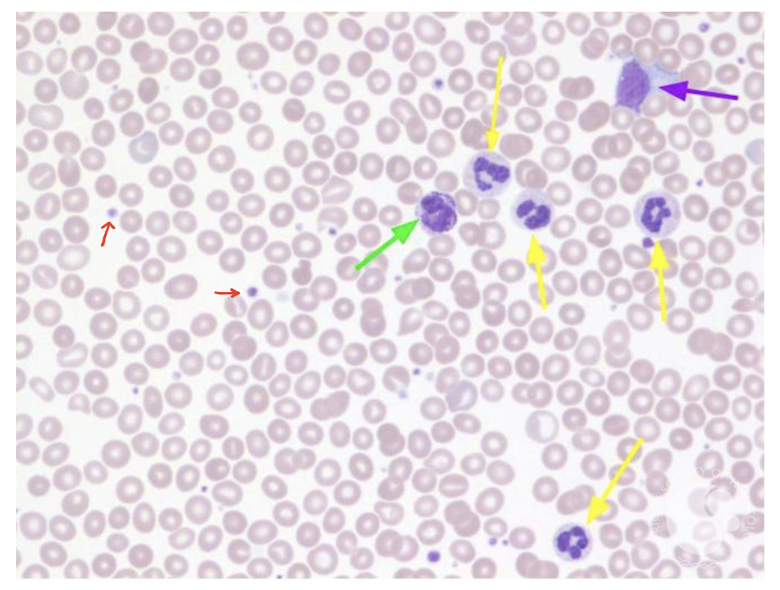
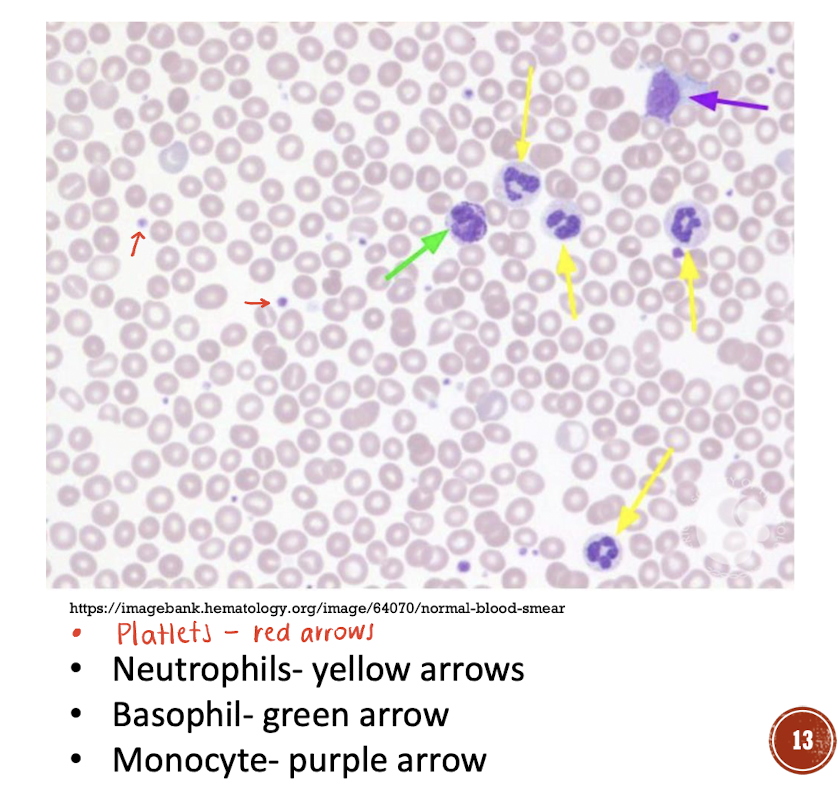
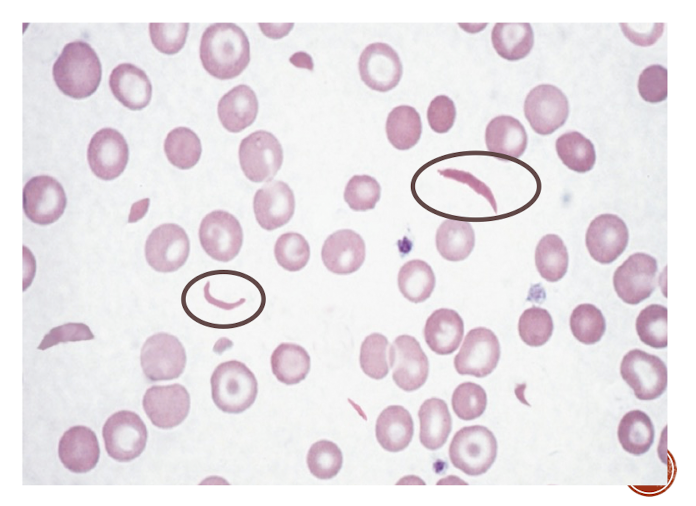
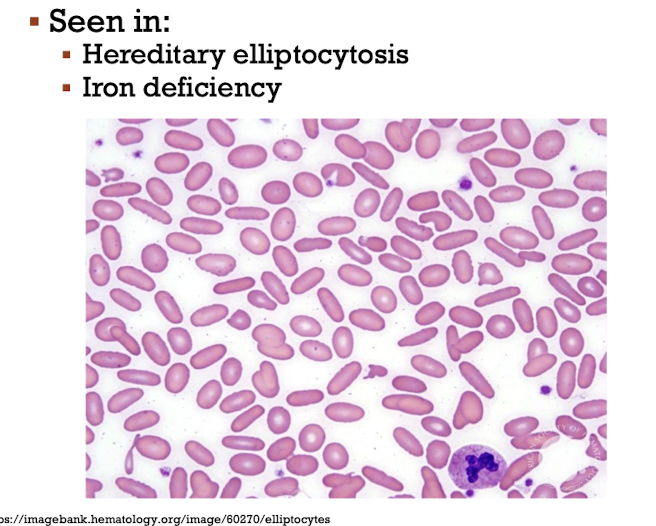
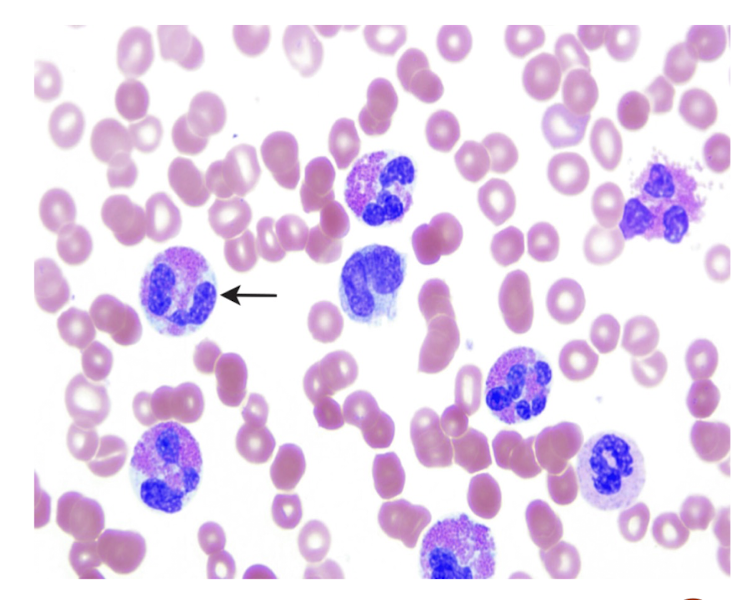
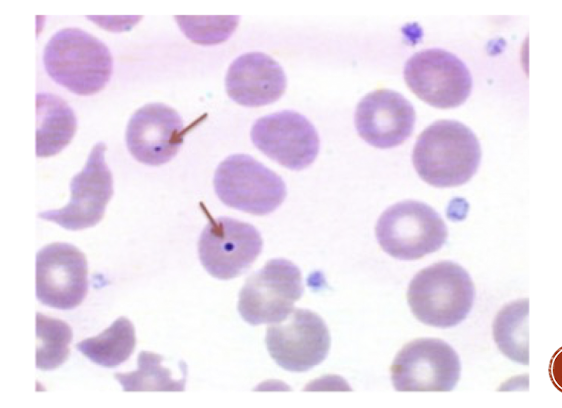
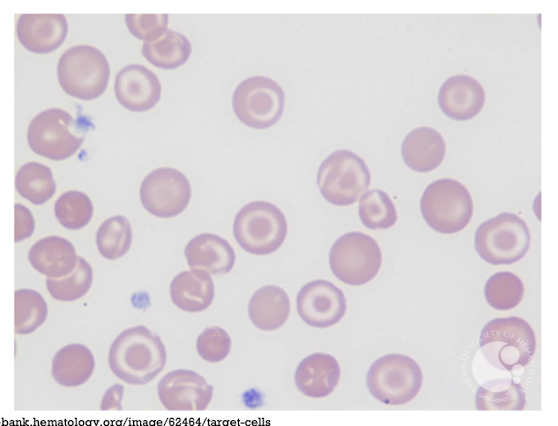
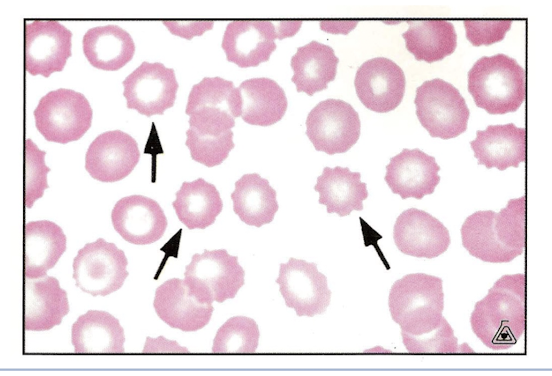
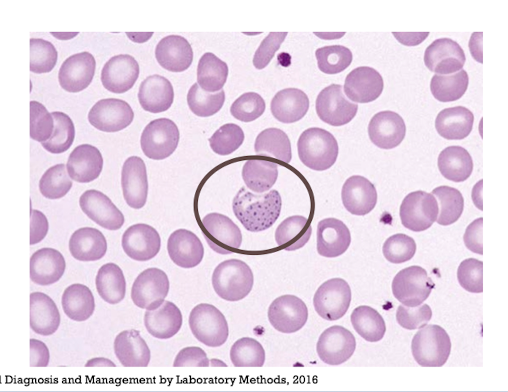

Identify the cells types present on the attached peripheral blood smear.
Red arrow - Platlets
Yellow arrow - Neutrophils
Green arrow - Basophils
Purple arrow - Monocytes
No arrow - RBCs
Macrocytic RBCs are most associated with what cause?
B12 or Folate Deficiency
CD16 & CD56 are most associated with what cells?
NK Cells
Patients with sickle cell disease have RBCs with a crescent appearance. What is the name for this RBC shape?
Drepanocytes
All T lymphocytes have this protein marker on their surface.
CD3
These are random clusters of RBCs.
Agglutination

Bone marrow cellularity naturally decreases with age. What replaces these stem cells?
Adipocytes

What are band cells?
Premature neutrophils
Monocytes mature into macrophages. How is their histologic appearance described?
Cells with an indented nucleus and ground-glass cytoplasm

These RBCs are twice as long as they are wide.
Elliptocytes
What are the contraindications to a bone marrow biopsy?
Inability to properly form clots, infection close to site, radiation exposure at site
A CBC is run and an RBC is described as microcytic. What lab result was utilized to make this classification?
Mean Corpuscular Volume (MCV)
Eosinophils contain granules with what enzyme?
Histaminase
Microcytic RBCs are most associated with what cause?
Iron deficiency
Howell-Jolly bodies are nuclear remnants in mature RBCs. In what patients are these most commonly found?
Patients without a spleen
What protein markers are located on all B lymphocytes?
CD19, CD20, CD21
How can codocytes be described?
AKA target cells - RBCs with a ring of central pallor surrounding a central circle of a hemoglobinized membrane
These histological findings are characteristic of G6PD.
Heinz Bodies and Bite Cells

RBCs are derived from what cell lineage?
Myeloid Stem Cells

What are the general indications for a bone marrow study?
Diagnosis of disease, staging of malignancy, monitoring treatment or disease progression
This RBC shape is characterized by spiny projections and central pallor.
Echinocytes (Burr Cells)
Basophilic stippling is due to clusters of RNA-containing ribosomes within RBCs. With what pathology are these most associated?
Lead Poisoning
True/False. Bone marrow biopsies produce fresh tissue.
False - tissue must be “fixed” due to calcification. Bone marrow aspiration provides fresh tissue
True/False. Red Cell Distribution Width (RDW) is a measure of variation in the size of RBCs. This value should be zero, except in cases of anemia.
False - RDW generally ranges from 11.5-14.5%. It increases in cases of anemia and liver disease.



